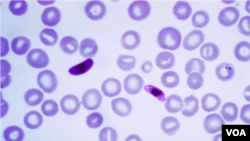
Parasit Plasmodium Falciparum, protozoa satu sel yang hidup dalam nyamuk dan menyebabkan tipe malaria yang paling mematikan, di antara sel-sel darah.

Sekelompok ilmuwan di Universitas Washington di St. Louis, Missouri, menghabiskan enam tahun dalam upaya mereka memahami struktur dan fungsi protein yang sangat penting untuk kelangsungan hidup Plasmodium Falciparum.
Ini adalah protozoa satu sel yang hidup dalam nyamuk dan menyebabkan tipe malaria yang paling mematikan. Parasit miskroskopis ini membutuhkan protein jenis ini – enzim yang disebut PMT – untuk membuat membran sel-selnya, dan tak dapat hidup tanpa protein ini.
Joseph Jez, yang memimpin tim penelitian, mengatakan bahwa memecahkan kode desain PMT ini seperti menemukan kelemahan fatal malaria.
"Jika kita dapat membidik protein tersebut dan pada dasarnya membunuh aktivitas protein tersebut, kita bisa mematikan produksi bahan dasar membran yang selanjutnya dapat mematikan organisme ini atau memperlambat pertumbuhannya,” paparnya.
Dr. Jez dan timnya menggunakan metode rumit yang disebut kristalisasi protein untuk dapat mengamati struktur molekul PMT dalam tiga dimensi. Ia mengatakan metode ini sangat penting untuk penelitian mereka.
"Jika kita dapat memahami bagaimana bentuk molekul ini dalam tiga dimensi, maka kita dapat membuat obat yang dapat membidik protein tersebut secara spesifik,” ujarnya.
Dr. Jez menambahkan bahwa karena Plasmodium PMT tidak dapat ditemukan dalam sel manusia, semua obat yang ditujukan pada protein ini dapat dengan aman diberikan kepada manusia.
Dr. Neeraj Mistry adalah direktur pelaksana Jaringan Global untuk Penyakit Tropis yang Terabaikan.Ia mengatakan bahwa riset ini merupakan langkah penting ke arah ditemukannya obat baru yang ampuh dan aman untuk memerangi wabah malaria.
"Penemuan ini membuka pintu ke arah pengembangan obat baru yang secara spesifik hanya akan mempengaruhi parasitnya. Hal ini juga berarti bahwa begitu jalan ini teridentifikasi, kita mungkin akan dapat menghasilkan obat yang unik, yang benar-benar mempengaruhi parasit malaria tersebut,” ujarnya.
Upaya untuk mengidentifikasi senyawa yang menarget Plasmodium PMT baru saja dimulai. Namun penelitian Universitas Washington ini memberi harapan baru, bukan saja untuk obat anti malaria baru, namun juga untuk zat yang dapat membasmi berbagai ulat parasit penyebab penyakit dan juga tumbuhan gulma yang semuanya bergantung pada protein PMT yang sama.